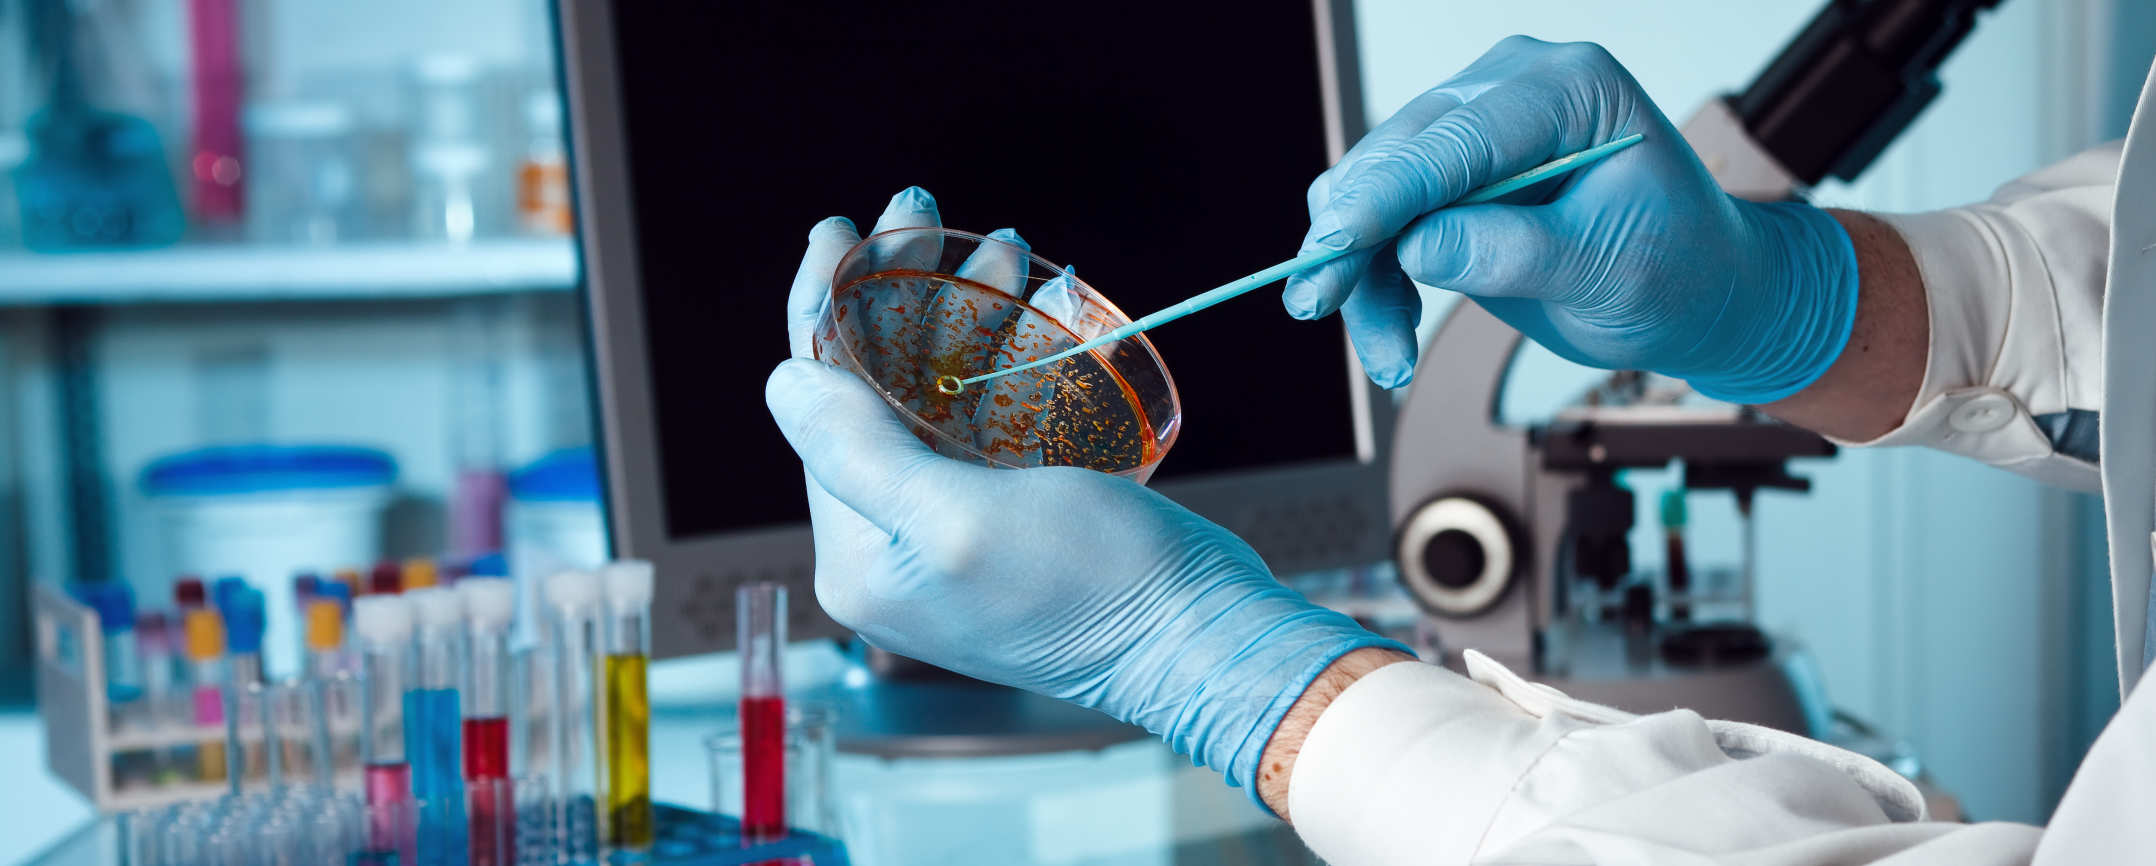

Project Topics For Microbiology Students Project Project 2016 Project2016 Excel PRD
Word Excel PowerPoint Visio Project Office2019 Word Excel PowerPoint Visio Microsoft Project Office
Project Topics For Microbiology Students
Project Topics For Microbiology Students
https://afribary.com/blog/wp-content/uploads/2022/06/food-microbiology-project-topics.png
Phd In Microbiology In Usa CollegeLearners
https://www.uab.edu/degrees/images/hero/microbiology-phd.jpg
12 Microbiology Technologist Skills Definition And Examples
https://cdn.resumecatstatic.com/resume-examples/microbiology-technologist-resume-example-m1xpG.png
pmp pmp pmi 200 1999 Then I closed the project Then I opened the workspace and readded all the code I wanted Made sure there were no errors Then closed the project Now delete the intermediate
So I went to get rid of the Substance plugin from my project I right clicked my uproject file and deleted the substance entry from plugins using Notepad When I MPP Project Project mpp mpp
More picture related to Project Topics For Microbiology Students
50 Best Microbiology Project Topics For Students Microscopic Adventures
https://creativeprojectideas.com/wp-content/uploads/2023/12/Microbiology-Project-Topics-for-Students.jpg
Microbiology Project Topics YouTube
https://i.ytimg.com/vi/wAJkCmWjVng/maxresdefault.jpg
Top 15 Microbiology Degree Jobs Career Sidekick
https://careersidekick.com/wp-content/uploads/2023/08/Microbiology-Degree-Guide-infographic.png
2011 1 Project Manager for Java Visual Studio IntelliCode Java Marketplace https
[desc-10] [desc-11]
Free Computer Engineering Project Topics For Final Year Students
https://projectng.com/image/computer-engineering-project-topics.jpg
Microbiology Project Seminar Proposal Topics And Materials
https://sparklyn.com.ng/Sparklyn/project/dept/dept/microbiology-project-and-seminar-material.jpg

https://www.zhihu.com › question
Project Project 2016 Project2016 Excel PRD

https://www.zhihu.com › question
Word Excel PowerPoint Visio Project Office2019 Word Excel PowerPoint Visio

Common Mistakes Microbiology Students Make How To Avoid Them

Free Computer Engineering Project Topics For Final Year Students

Microbiology Thesis Ideas Thesis Ideas
Activities Imperial College London

CBSE Class 10 DELETED Syllabus 2022 2023 Download Class 10th Subject

Biology Science Project Ideas

Biology Science Project Ideas

100 Creative Marketing Project Topics For Students

Microbiology Ppt Templates

PDF Seminar Topics For Microbiology Students In Nigeria
Project Topics For Microbiology Students - pmp pmp pmi 200 1999